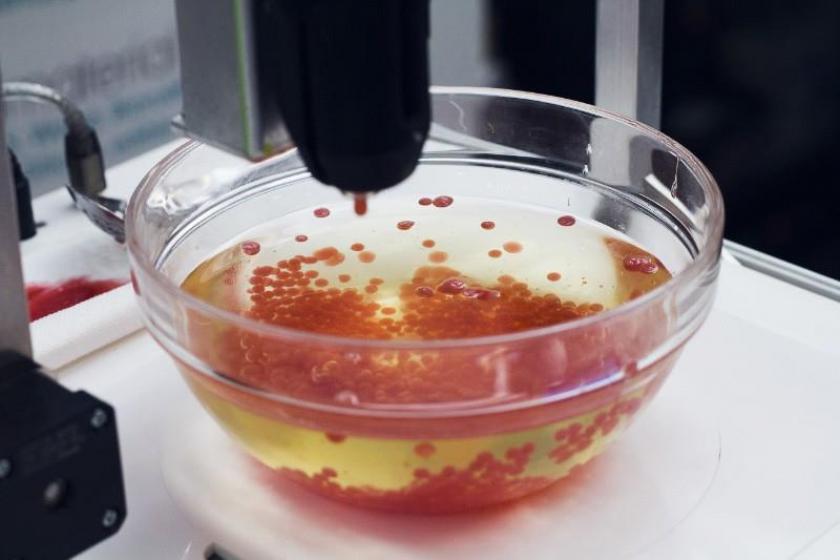

В Лондоне открыли ресторан с едой из 3D-принтера
В Лондоне (Великобритания) открылся первый в мире ресторан Food Ink, в котором все создано при помощи 3D-технологии.
Об єтом сообщает ГОРДОН со ссылкой на ArchDaily.
На принтере напечатаны столы, стулья, скатерти, посуда и все блюда меню. В заведении работают не только повара, но и художники, дизайнеры и инженеры.
Все блюда создаются из специальных пищевых "чернил", которые изготавливают методом прессования продуктов в пасту, и подаются на напечатанных здесь же пластиковых приборах.
За первые семь минут после начала онлайн-бронирования столиков в Food Ink все места были забронированы на три дня вперед. Ресторан может принимать только 10 гостей.
Дегустационное меню состоит из девяти блюд. В целом, стоимость одного блюда составляет около 330 долларов.